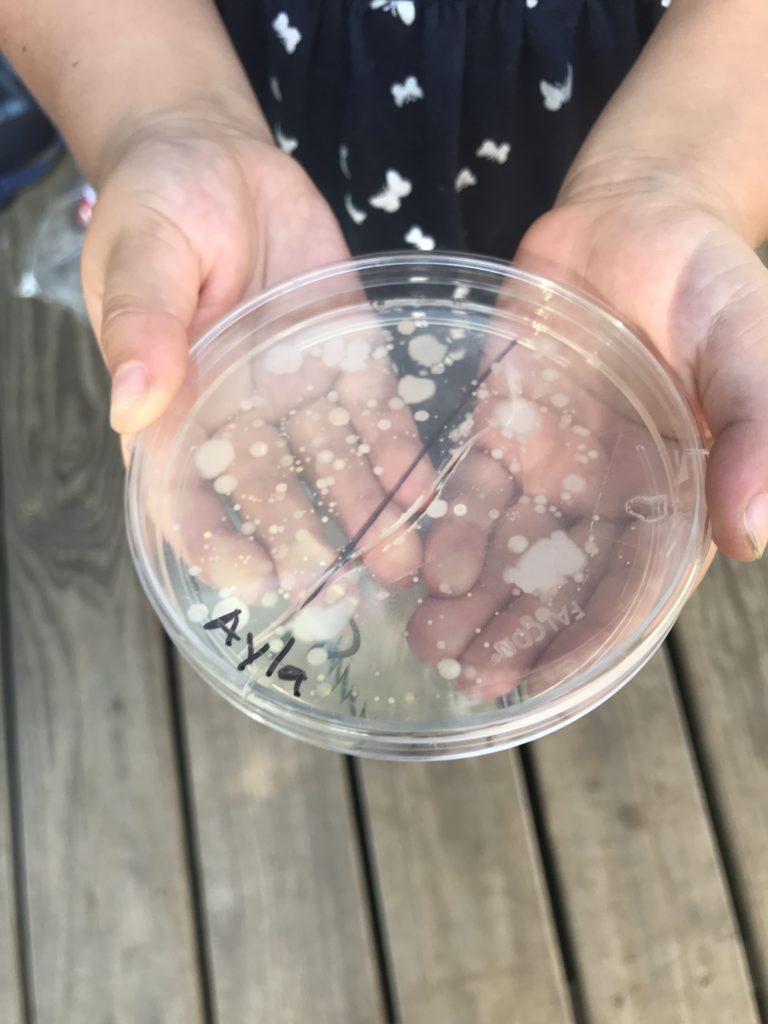
Handwash3

Like many Montessori Schools, we go out of our way to celebrate birthdays. We do so in a way that emphasizes the passage of time a child’s life. The children discuss how the Earth goes around the sun each year, getting an idea of their place in time. Essentially these are among the first History and Science lessons […]